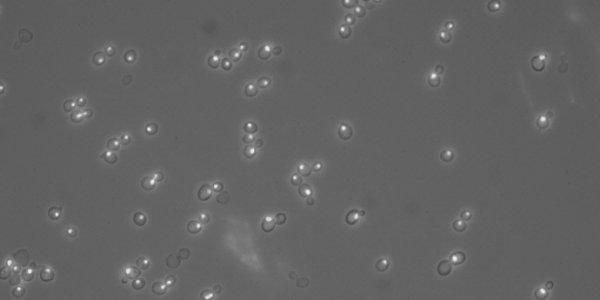
The Secret Life of Brewer's Yeast

Is Love At First Sight Real? A Genetic Clue
Geneticists have tackled a question that has perplexed humanity since the dawn of time: does love at first sight truly exist?
Maybe, according to a study published in the April 2009 issue of the…